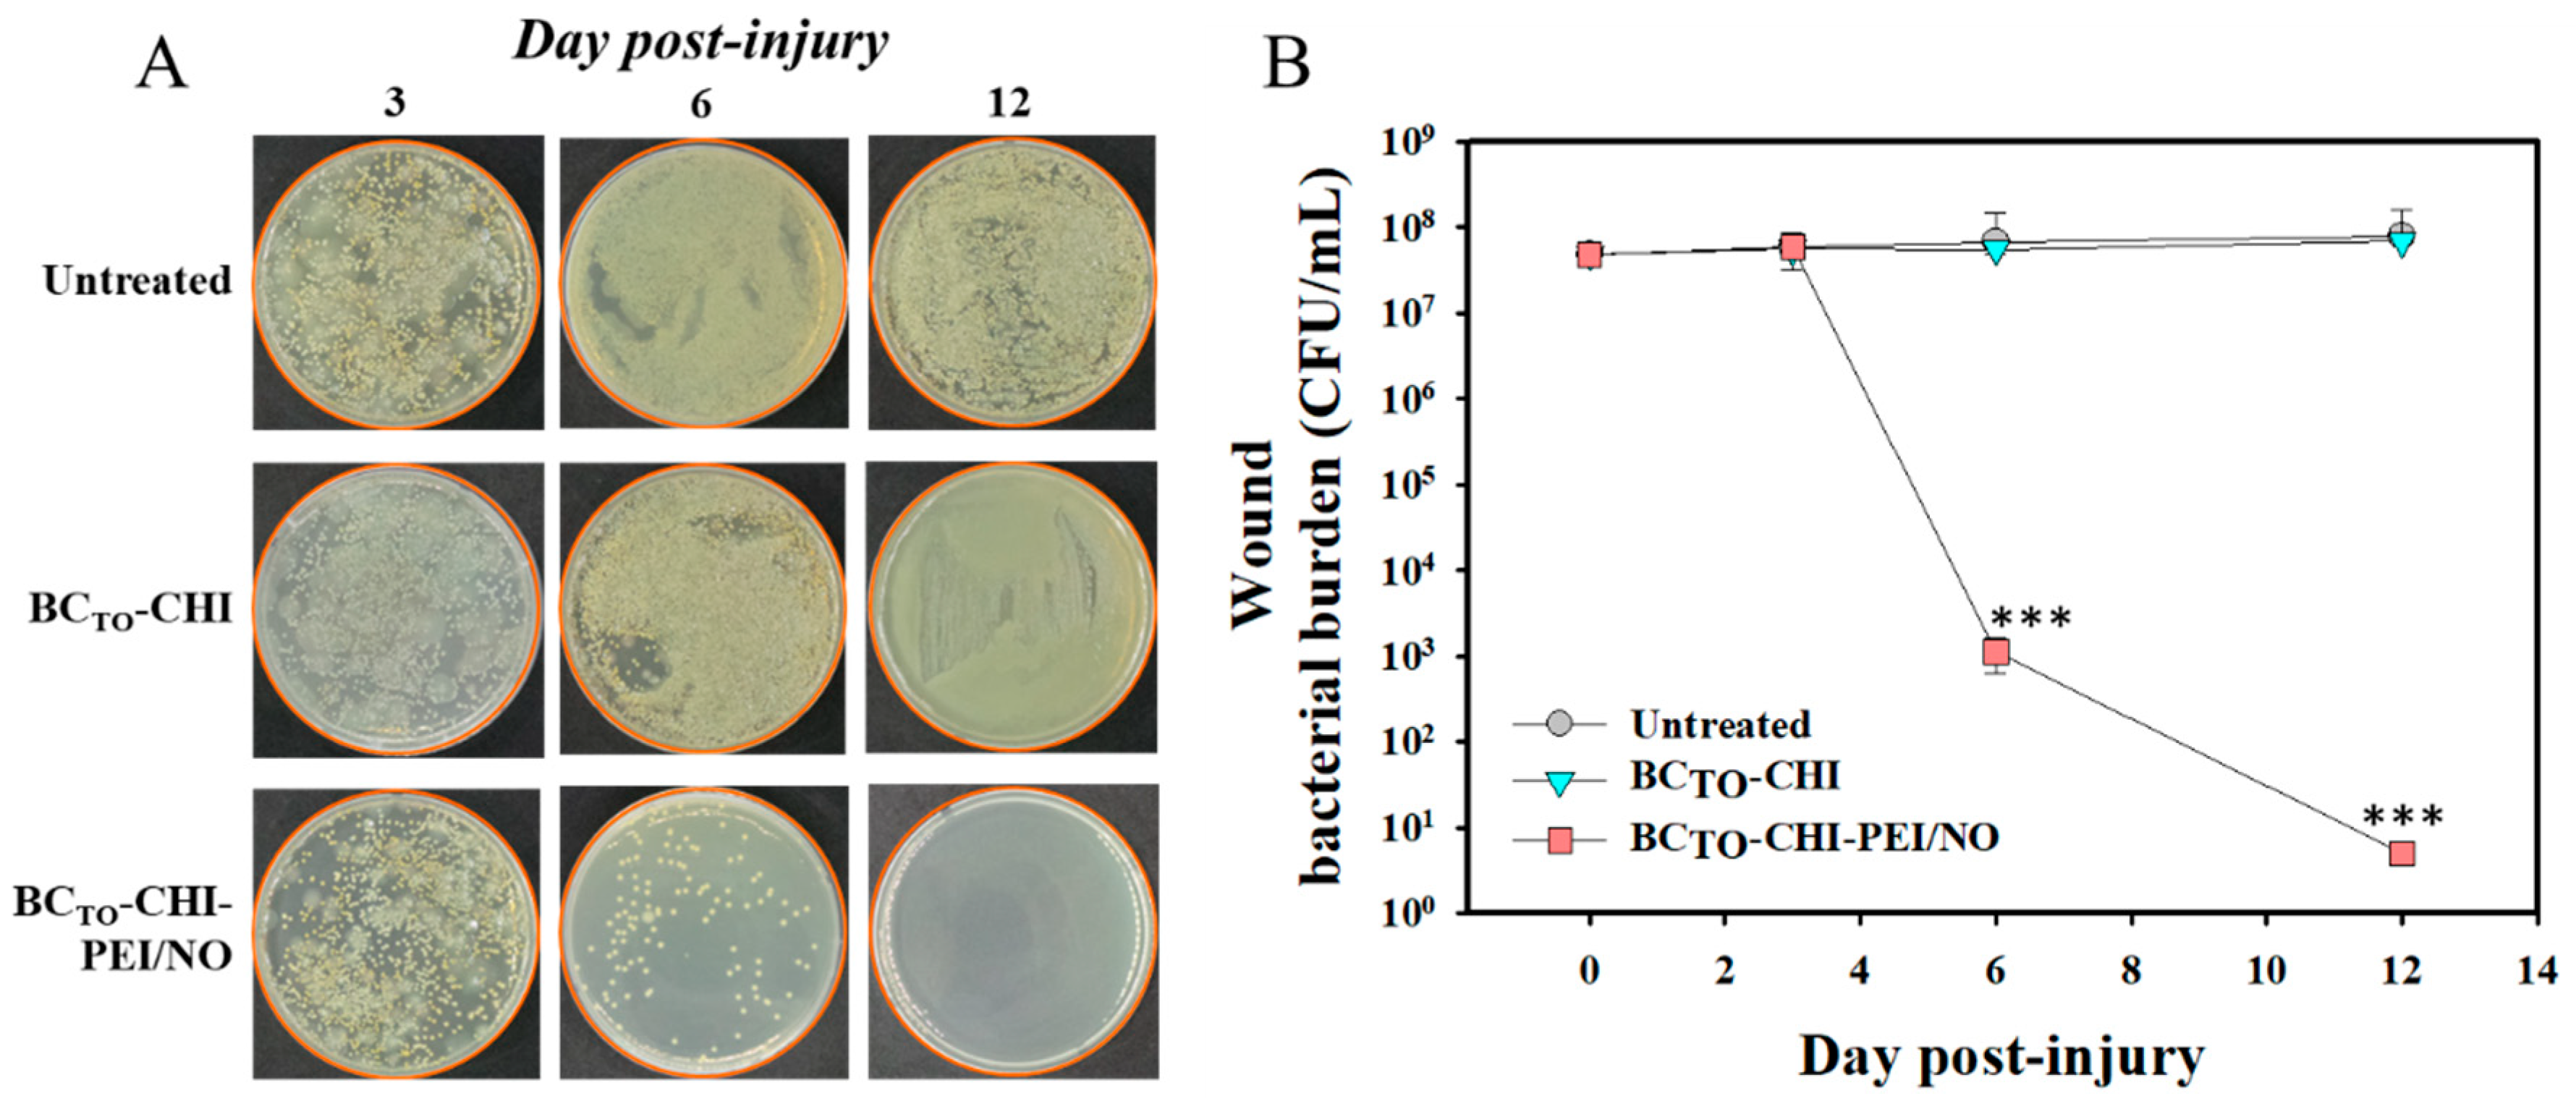

Nitric Oxide-Releasing Bacterial Cellulose/Chitosan Crosslinked Hydrogels for the Treatment of Polymicrobial Wound Infections
Abstract
1. Introduction
2. Materials and Methods
2.1. Materials
2.2. Preparation of Bacterial Cellulose
2.3. Preparation of Oxidized Bacterial Cellulose via TEMPO Reaction
2.4. Preparation of Crosslinked Hydrogels
2.5. Characterization
2.5.1. Scanning Electron Microscopy (SEM)
2.5.2. Fourier Transform Infrared Spectroscopy (FTIR)
2.6. Rheological Properties
2.7. In Vitro Nitric Oxide Release
2.8. In Vitro Antibacterial Study
2.9. In Vitro Cytotoxicity Study
2.10. In Vivo Wound Healing Assay
2.11. Reduction of Wound Bacterial Burden
2.12. Statistical Analysis
3. Results and Discussion
3.1. Morphological Analysis of BC and BCTO
3.2. Morphological Analysis of BCTO and BCTO-CHI-PEI/NO Hydrogels
3.3. FTIR Analysis
3.4. Rheological Properties
3.5. In Vitro Drug Release
3.6. In Vitro Antibacterial Activity of Hydrogels
3.7. In Vitro Cytotoxicity Study
3.8. In Vivo Wound Healing Assay
3.9. Reduction of Wound Bacterial Burden
4. Conclusions
Author Contributions
Funding
Institutional Review Board Statement
Informed Consent Statement
Conflicts of Interest
References
- Bertesteanu, S.; Triaridis, S.; Stankovic, M.; Lazar, V.; Chifiriuc, M.C.; Vlad, M.; Grigore, R. Polymicrobial wound infections: Pathophysiology and current therapeutic approaches. Int. J. Pharm. 2014, 463, 119–126. [Google Scholar] [CrossRef] [PubMed]
- Bansal, E.; Garg, A.; Bhatia, S.; Attri, A.K.; Chander, J. Spectrum of microbial flora in diabetic foot ulcers. Indian J. Pathol. Microbiol. 2008, 51, 204. [Google Scholar] [PubMed]
- Yadav, M.K.; Chae, S.-W.; Go, Y.Y.; Im, G.J.; Song, J.-J. In vitro multi-species biofilms of methicillin-resistant Staphylococcus aureus and Pseudomonas aeruginosa and their host interaction during in vivo colonization of an otitis media rat model. Front. Cell. Infect. Microbiol. 2017, 7, 125. [Google Scholar] [CrossRef] [PubMed]
- Brogden, K.A.; Guthmiller, J.M.; Taylor, C.E. Human polymicrobial infections. Lancet 2005, 365, 253–255. [Google Scholar] [CrossRef]
- Chellan, G.; Shivaprakash, S.; Karimassery Ramaiyar, S.; Varma, A.K.; Varma, N.; Thekkeparambil Sukumaran, M.; Rohinivilasam Vasukutty, J.; Bal, A.; Kumar, H. Spectrum and prevalence of fungi infecting deep tissues of lower-limb wounds in patients with type 2 diabetes. J. Clin. Microbiol. 2010, 48, 2097–2102. [Google Scholar] [CrossRef] [PubMed]
- Pastar, I.; Nusbaum, A.G.; Gil, J.; Patel, S.B.; Chen, J.; Valdes, J.; Stojadinovic, O.; Plano, L.R.; Tomic-Canic, M.; Davis, S.C. Interactions of methicillin resistant Staphylococcus aureus USA300 and Pseudomonas aeruginosa in polymicrobial wound infection. PLoS ONE 2013, 8, e56846. [Google Scholar] [CrossRef] [PubMed]
- Zubair, M.; Malik, A.; Ahmad, J. Incidence, risk factors for amputation among patients with diabetic foot ulcer in a North Indian tertiary care hospital. Foot 2012, 22, 24–30. [Google Scholar] [CrossRef]
- Lee, J.; Kwak, D.; Kim, H.; Kim, J.; Hlaing, S.P.; Hasan, N.; Cao, J.; Yoo, J.-W. Nitric Oxide-Releasing S-Nitrosoglutathione-Conjugated Poly(Lactic-Co-Glycolic Acid) Nanoparticles for the Treatment of MRSA-Infected Cutaneous Wounds. Pharmaceutics 2020, 12, 618. [Google Scholar] [CrossRef]
- Hlaing, S.P.; Kim, J.; Lee, J.; Hasan, N.; Cao, J.; Naeem, M.; Lee, E.H.; Shin, J.H.; Jung, Y.; Lee, B.-L.; et al. S-Nitrosoglutathione loaded poly(lactic-co-glycolic acid) microparticles for prolonged nitric oxide release and enhanced healing of methicillin-resistant Staphylococcus aureus-infected wounds. Eur. J. Pharm. Biopharm. 2018, 132, 94–102. [Google Scholar] [CrossRef]
- Hasan, N.; Cao, J.; Lee, J.; Naeem, M.; Hlaing, S.P.; Kim, J.; Jung, Y.; Lee, B.-L.; Yoo, J.-W. PEI/NONOates-doped PLGA nanoparticles for eradicating methicillin-resistant Staphylococcus aureus biofilm in diabetic wounds via binding to the biofilm matrix. Mater. Sci. Eng. C 2019, 103, 109741. [Google Scholar] [CrossRef]
- Hasan, N.; Lee, J.; Kwak, D.; Kim, H.; Saparbayeva, A.; Ahn, H.-J.; Yoon, I.-S.; Kim, M.-S.; Jung, Y.; Yoo, J.-W. Diethylenetriamine/NONOate-doped alginate hydrogel with sustained nitric oxide release and minimal toxicity to accelerate healing of MRSA-infected wounds. Carbohydr. Polym. 2021, 270, 118387. [Google Scholar] [CrossRef]
- Hasan, N.; Cao, J.; Lee, J.; Hlaing, S.P.; Oshi, M.A.; Naeem, M.; Ki, M.-H.; Lee, B.L.; Jung, Y.; Yoo, J.-W. Bacteria-Targeted Clindamycin Loaded Polymeric Nanoparticles: Effect of Surface Charge on Nanoparticle Adhesion to MRSA, Antibacterial Activity, and Wound Healing. Pharmaceutics 2019, 11, 236. [Google Scholar] [CrossRef]
- Lee, J.; Hlaing, S.P.; Cao, J.; Hasan, N.; Yoo, J.-W. In vitro and in vivo evaluation of a novel nitric oxide-releasing ointment for the treatment of methicillin-resistant Staphylococcus aureus-infected wounds. J. Pharm. Investig. 2020, 50, 505–512. [Google Scholar] [CrossRef]
- Choi, M.; Hasan, N.; Cao, J.; Lee, J.; Hlaing, S.P.; Yoo, J.-W. Chitosan-based nitric oxide-releasing dressing for anti-biofilm and in vivo healing activities in MRSA biofilm-infected wounds. Int. J. Biol. Macromol. 2020, 142, 680–692. [Google Scholar] [CrossRef] [PubMed]
- Cao, J.; Su, M.; Hasan, N.; Lee, J.; Kwak, D.; Kim, D.Y.; Kim, K.; Lee, E.H.; Jung, J.H.; Yoo, J.-W. Nitric Oxide-Releasing Thermoresponsive Pluronic F127/Alginate Hydrogel for Enhanced Antibacterial Activity and Accelerated Healing of Infected Wounds. Pharmaceutics 2020, 12, 926. [Google Scholar] [CrossRef] [PubMed]
- Lee, J.; Hlaing, S.P.; Cao, J.; Hasan, N.; Ahn, H.-J.; Song, K.-W.; Yoo, J.-W. In situ hydrogel-forming/nitric oxide-releasing wound dressing for enhanced antibacterial activity and healing in mice with infected wounds. Pharmaceutics 2019, 11, 496. [Google Scholar] [CrossRef]
- Seabra, A.B.; Pelegrino, M.T.; Haddad, P.S. Can nitric oxide overcome bacterial resistance to antibiotics. In Antibiotic Resistance; Elsevier: Amsterdam, The Netherlands, 2016; pp. 187–204. [Google Scholar]
- Rouillard, K.R.; Novak, O.P.; Pistiolis, A.M.; Yang, L.; Ahonen, M.J.R.; McDonald, R.A.; Schoenfisch, M.H. Exogenous nitric oxide improves antibiotic susceptibility in resistant bacteria. ACS Infect. Dis. 2020, 7, 23–33. [Google Scholar] [CrossRef] [PubMed]
- Verma, P.; Thakur, A.S.; Deshmukh, K.; Jha, A.K.; Verma, S. Routes of drug administration. Int. J. Pharm. Stud. Res. 2010, 1, 54–59. [Google Scholar]
- Peppas, N.A.; Hilt, J.Z.; Khademhosseini, A.; Langer, R. Hydrogels in biology and medicine: From molecular principles to bionanotechnology. Adv. Mater. 2006, 18, 1345–1360. [Google Scholar] [CrossRef]
- Hasan, N.; Cao, J.; Lee, J.; Kim, H.; Yoo, J.-W. Development of clindamycin-loaded alginate/pectin/hyaluronic acid composite hydrogel film for the treatment of MRSA-infected wounds. J. Pharm. Investig. 2021, 51, 597–610. [Google Scholar] [CrossRef]
- Haidari, H.; Bright, R.; Garg, S.; Vasilev, K.; Cowin, A.J.; Kopecki, Z. Eradication of Mature Bacterial Biofilms with Concurrent Improvement in Chronic Wound Healing Using Silver Nanoparticle Hydrogel Treatment. Biomedicines 2021, 9, 1182. [Google Scholar] [CrossRef] [PubMed]
- Haidari, H.; Bright, R.; Strudwick, X.L.; Garg, S.; Vasilev, K.; Cowin, A.J.; Kopecki, Z. Multifunctional ultrasmall AgNP hydrogel accelerates healing of S. aureus infected wounds. Acta Biomater. 2021, 128, 420–434. [Google Scholar] [CrossRef] [PubMed]
- Drury, J.L.; Mooney, D.J. Hydrogels for tissue engineering: Scaffold design variables and applications. Biomaterials 2003, 24, 4337–4351. [Google Scholar] [CrossRef]
- Elsner, J.J.; Shefy-Peleg, A.; Zilberman, M. Novel biodegradable composite wound dressings with controlled release of antibiotics: Microstructure, mechanical and physical properties. J. Biomed. Mater. Res. Part B Appl. Biomater. 2010, 93, 425–435. [Google Scholar] [CrossRef] [PubMed]
- Bodin, A.; Concaro, S.; Brittberg, M.; Gatenholm, P. Bacterial cellulose as a potential meniscus implant. J. Tissue Eng. Regen. Med. 2007, 1, 406–408. [Google Scholar] [CrossRef]
- Bäckdahl, H.; Esguerra, M.; Delbro, D.; Risberg, B.; Gatenholm, P. Engineering microporosity in bacterial cellulose scaffolds. J. Tissue Eng. Regen. Med. 2008, 2, 320–330. [Google Scholar] [CrossRef]
- Hasan, N.; Rahman, L.; Kim, S.-H.; Cao, J.; Arjuna, A.; Lallo, S.; Jhun, B.H.; Yoo, J.-W. Recent advances of nanocellulose in drug delivery systems. J. Pharm. Investig. 2020, 50, 553–572. [Google Scholar] [CrossRef]
- Peng, S.; Zheng, Y.; Wu, J.; Wu, Y.; Ma, Y.; Song, W.; Xi, T. Preparation and characterization of degradable oxidized bacterial cellulose reacted with nitrogen dioxide. Polym. Bull. 2012, 68, 415–423. [Google Scholar] [CrossRef]
- Ifuku, S.; Tsuji, M.; Morimoto, M.; Saimoto, H.; Yano, H. Synthesis of silver nanoparticles templated by TEMPO-mediated oxidized bacterial cellulose nanofibers. Biomacromolecules 2009, 10, 2714–2717. [Google Scholar] [CrossRef]
- Giri, B.R.; Poudel, S.; Kim, D.W. Cellulose and its derivatives for application in 3D printing of pharmaceuticals. J. Pharm. Investig. 2021, 51, 1–22. [Google Scholar] [CrossRef]
- Czaja, W.K.; Young, D.J.; Kawecki, M.; Brown, R.M. The future prospects of microbial cellulose in biomedical applications. Biomacromolecules 2007, 8, 1–12. [Google Scholar] [CrossRef]
- Anton-Sales, I.; Beekmann, U.; Laromaine, A.; Roig, A.; Kralisch, D. Opportunities of bacterial cellulose to treat epithelial tissues. Curr. Drug Targets 2019, 20, 808–822. [Google Scholar] [CrossRef] [PubMed]
- Hoemann, C.D.; Chenite, A.; Sun, J.; Hurtig, M.; Serreqi, A.; Lu, Z.; Rossomacha, E.; Buschmann, M.D. Cytocompatible gel formation of chitosan-glycerol phosphate solutions supplemented with hydroxyl ethyl cellulose is due to the presence of glyoxal. J. Biomed. Mater. Res. Part A 2007, 83, 521–529. [Google Scholar] [CrossRef] [PubMed]
- Fontana, C.R.; dos Santos Junior, D.S.; Bosco, J.M.; Spolidorio, D.M.; Chierici Marcantonio, R.A. Evaluation of chitosan gel as antibiotic and photosensitizer delivery. Drug Deliv. 2008, 15, 417–422. [Google Scholar] [CrossRef]
- Yoo, J.-Y.; Jang, E.-Y.; Son, Y.-J.; Park, S.-Y.; Son, H.-J. Isolation and Characterization of Bacterial Cellulose-Producing Bacteria for Silver Nanoparticle Synthesis. Microbiol. Biotechnol. Lett. 2018, 46, 120–126. [Google Scholar] [CrossRef]
- Luo, H.; Xiong, G.; Hu, D.; Ren, K.; Yao, F.; Zhu, Y.; Gao, C.; Wan, Y. Characterization of TEMPO-oxidized bacterial cellulose scaffolds for tissue engineering applications. Mater. Chem. Phys. 2013, 143, 373–379. [Google Scholar] [CrossRef]
- Glessner, A.; Smith, R.S.; Iglewski, B.H.; Robinson, J.B. Roles of Pseudomonas aeruginosa las and rhl quorum-sensing systems in control of twitching motility. J. Bacteriol. 1999, 181, 1623–1629. [Google Scholar] [CrossRef]
- Kreiswirth, B.N.; Löfdahl, S.; Betley, M.J.; O’Reilly, M.; Schlievert, P.M.; Bergdoll, M.S.; Novick, R.P. The toxic shock syndrome exotoxin structural gene is not detectably transmitted by a prophage. Nature 1983, 305, 709–712. [Google Scholar] [CrossRef]
- Pati, B.A.; Kurata, W.E.; Horseman, T.S.; Pierce, L.M. Antibiofilm activity of chitosan/epsilon-poly-L-lysine hydrogels in a porcine ex vivo skin wound polymicrobial biofilm model. Wound Repair Regen. 2021, 29, 316–326. [Google Scholar] [CrossRef]
- Mao, L.; Wang, L.; Zhang, M.; Ullah, M.W.; Liu, L.; Zhao, W.; Li, Y.; Ahmed, A.A.Q.; Cheng, H.; Shi, Z. In Situ Synthesized Selenium Nanoparticles-Decorated Bacterial Cellulose/Gelatin Hydrogel with Enhanced Antibacterial, Antioxidant, and Anti-Inflammatory Capabilities for Facilitating Skin Wound Healing. Adv. Healthc. Mater. 2021, 10, 2100402. [Google Scholar] [CrossRef]
- Liu, H.; Wang, C.; Li, C.; Qin, Y.; Wang, Z.; Yang, F.; Li, Z.; Wang, J. A functional chitosan-based hydrogel as a wound dressing and drug delivery system in the treatment of wound healing. RSC Adv. 2018, 8, 7533–7549. [Google Scholar] [CrossRef]
- Ahmed, J.; Gultekinoglu, M.; Edirisinghe, M. Bacterial cellulose micro-nano fibres for wound healing applications. Biotechnol. Adv. 2020, 41, 107549. [Google Scholar] [CrossRef] [PubMed]
- Nurhasni, H.; Cao, J.; Choi, M.; Kim, I.; Lee, B.L.; Jung, Y.; Yoo, J.-W. Nitric oxide-releasing poly (lactic-co-glycolic acid)-polyethylenimine nanoparticles for prolonged nitric oxide release, antibacterial efficacy, and in vivo wound healing activity. Int. J. Nanomed. 2015, 10, 3065. [Google Scholar]
- Matthews, K.H.; Stevens, H.N.E.; Auffret, A.D.; Humphrey, M.J.; Eccleston, G.M. Gamma-irradiation of lyophilised wound healing wafers. Int. J. Pharm. 2006, 313, 78–86. [Google Scholar] [CrossRef] [PubMed]
- Wynne, R.; Botti, M.; Stedman, H.; Holsworth, L.; Harinos, M.; Flavell, O.; Manterfield, C. Effect of Three Wound Dressings on Infection, Healing Comfort, and Cost in Patients with Sternotomy Wounds: A Randomized Trial. Chest 2004, 125, 43–49. [Google Scholar] [CrossRef] [PubMed]
- Lin, C.-C.; Metters, A.T. Hydrogels in controlled release formulations: Network design and mathematical modeling. Adv. Drug Deliv. Rev. 2006, 58, 1379–1408. [Google Scholar] [CrossRef] [PubMed]
- Hoang Thi, T.T.; Lee, Y.; Le Thi, P.; Park, K.D. Nitric oxide-releasing injectable hydrogels with high antibacterial activity through in situ formation of peroxynitrite. Acta Biomater. 2018, 67, 66–78. [Google Scholar] [CrossRef] [PubMed]
- Kim, J.O.; Noh, J.-K.; Thapa, R.K.; Hasan, N.; Choi, M.; Kim, J.H.; Lee, J.-H.; Ku, S.K.; Yoo, J.-W. Nitric oxide-releasing chitosan film for enhanced antibacterial and in vivo wound-healing efficacy. Int. J. Biol. Macromol. 2015, 79, 217–225. [Google Scholar] [CrossRef]
- Schairer, D.O.; Chouake, J.S.; Nosanchuk, J.D.; Friedman, A.J. The potential of nitric oxide releasing therapies as antimicrobial agents. Virulence 2012, 3, 271–279. [Google Scholar] [CrossRef]
- Goy, R.C.; Britto, D.d.; Assis, O.B.G. A review of the antimicrobial activity of chitosan. Polímeros 2009, 19, 241–247. [Google Scholar] [CrossRef]
- Yilmaz Atay, H. Antibacterial Activity of Chitosan-Based Systems. In Functional Chitosan; Jana, S., Jana, S., Eds.; Springer: Singapore, 2019; pp. 457–489. [Google Scholar] [CrossRef]
- Wong, T.; McGrath, J.A.; Navsaria, H. The role of fibroblasts in tissue engineering and regeneration. Br. J. Dermatol. 2007, 156, 1149–1155. [Google Scholar] [CrossRef] [PubMed]
- Krischel, V.; Bruch-Gerharz, D.; Suschek, C.; Kröncke, K.-D.; Ruzicka, T.; Kolb-Bachofen, V. Biphasic effect of exogenous nitric oxide on proliferation and differentiation in skin derived keratinocytes but not fibroblasts. J. Investig. Dermatol. 1998, 111, 286–291. [Google Scholar] [CrossRef] [PubMed]
- Li, Q.; Yang, D.; Ma, G.; Xu, Q.; Chen, X.; Lu, F.; Nie, J. Synthesis and characterization of chitosan-based hydrogels. Int. J. Biol. Macromol. 2009, 44, 121–127. [Google Scholar] [CrossRef]
- Mohamad, N.; Amin, M.C.I.M.; Pandey, M.; Ahmad, N.; Rajab, N.F. Bacterial cellulose/acrylic acid hydrogel synthesized via electron beam irradiation: Accelerated burn wound healing in an animal model. Carbohydr. Polym. 2014, 114, 312–320. [Google Scholar] [CrossRef] [PubMed]

| t[NO] a (μmoles/mg) | [NO]max b (ppb/mg) | t1/2 c (h) | td d (h) | |
|---|---|---|---|---|
| PEI/NO | 8.21 ± 1.48 | 3403.84 ± 646.73 | 1.53 ± 0.07 | 11.52 ± 2.19 |
| BCTO-CHI-PEI/NO | 2.54 ± 0.41 | 1271.89 ± 267.10 | 10.03 ± 0.87 | 111.95 ± 23.51 |
Publisher’s Note: MDPI stays neutral with regard to jurisdictional claims in published maps and institutional affiliations. |
© 2021 by the authors. Licensee MDPI, Basel, Switzerland. This article is an open access article distributed under the terms and conditions of the Creative Commons Attribution (CC BY) license (https://creativecommons.org/licenses/by/4.0/).
Share and Cite
Hasan, N.; Lee, J.; Ahn, H.-J.; Hwang, W.R.; Bahar, M.A.; Habibie, H.; Amir, M.N.; Lallo, S.; Son, H.-J.; Yoo, J.-W. Nitric Oxide-Releasing Bacterial Cellulose/Chitosan Crosslinked Hydrogels for the Treatment of Polymicrobial Wound Infections. Pharmaceutics 2022, 14, 22. https://doi.org/10.3390/pharmaceutics14010022
Hasan N, Lee J, Ahn H-J, Hwang WR, Bahar MA, Habibie H, Amir MN, Lallo S, Son H-J, Yoo J-W. Nitric Oxide-Releasing Bacterial Cellulose/Chitosan Crosslinked Hydrogels for the Treatment of Polymicrobial Wound Infections. Pharmaceutics. 2022; 14(1):22. https://doi.org/10.3390/pharmaceutics14010022
Chicago/Turabian StyleHasan, Nurhasni, Juho Lee, Hye-Jin Ahn, Wook Ryol Hwang, Muhammad Akbar Bahar, Habibie Habibie, Muhammad Nur Amir, Subehan Lallo, Hong-Joo Son, and Jin-Wook Yoo. 2022. "Nitric Oxide-Releasing Bacterial Cellulose/Chitosan Crosslinked Hydrogels for the Treatment of Polymicrobial Wound Infections" Pharmaceutics 14, no. 1: 22. https://doi.org/10.3390/pharmaceutics14010022
APA StyleHasan, N., Lee, J., Ahn, H.-J., Hwang, W. R., Bahar, M. A., Habibie, H., Amir, M. N., Lallo, S., Son, H.-J., & Yoo, J.-W. (2022). Nitric Oxide-Releasing Bacterial Cellulose/Chitosan Crosslinked Hydrogels for the Treatment of Polymicrobial Wound Infections. Pharmaceutics, 14(1), 22. https://doi.org/10.3390/pharmaceutics14010022

